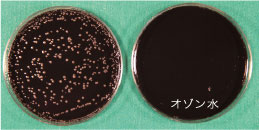
Campylobacter jejuni (カンピロバクター菌)
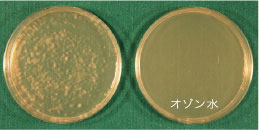
Trichophyton rubrum (白癬菌)

オゾン水の除菌・不活化効果
-
細菌に対するオゾン水の除菌効果
北里大学医学部にて行われたユニゾーンの除菌試験にて、下図の細菌が5秒間に106 個/mLも除菌されることが確認されました。夏場の食中毒の原因となる腸炎ビブリオやリステリア菌、白癬菌(水虫)、アクネ菌(にきび)も、オゾン水に接触すると瞬時に除菌されます。

Escherichia coli ATCC25922
(大腸菌)
Escherichia coli 0 -111
(病原大腸菌)
Staphlococcus aureus ATCC25923
(黄色ブドウ球菌)
Salmonella typimurium
(サルモネラ菌)
Propionibacterium acnes
(アクネ菌)
Sigella flexneri
(赤痢菌)
Vibrio Parahaemolyticus
(腸炎ビブリオ菌)
Listeria monocytogenes EGD
(リステリア菌)
Pseudomonas aeruginosa
(緑膿菌)
Enterococcus faecalis
(エンテロコッカス)
Serratia marcescens
(セラチア菌)
Yersinia enterocolitica
(エルシニア菌)
Campylobacter jejuni
(カンピロバクター菌)
Streptococcus mutanns
(ミュータンス菌)
Trichophyton rubrum
(白癬菌)オゾン水:オゾン水と反応させたもの
-
ウイルスに対するオゾン水の不活化効果
北里大学によれば、ユニゾーンで生成されたオゾン水は、ノロウイルス・インフルエンザウイルスを30秒で99.8%不活化しました。新型コロナウイルスについても、各医科大学において各々の試験方法でオゾン水の不活化効果が確認されています。
ウイルスの種類 オゾン水濃度
mg/L微生物濃度
個/mLpH
-温度
℃接触時間
秒残存
-インフルエンザウイルス 1 105.3EID50 7 21 5 - 鶏脳脊髄炎ウイルス 1 102.5EID50 7 21 5 - 犬伝染性肝炎ウイルス 1 101.5TCID50 7 21 5 - 犬パルボウイルス 1 102.5TCID50 7 21 5 - -:不検出
日本医療・環境オゾン研究会「環境分野におけるオゾン利用の実際」(2007年)より他の除菌効果物質との比較
オゾン水 次亜塩素酸
ナトリウム溶液微酸性次亜塩素酸水 pH ほぼ中性(原水依存) アルカリ性 弱酸性(pH5~6.5) 殺菌目的での
一般的な使用濃度0.3~4ppm以上
と薄い50~600ppm 10~80ppm 効能を発揮する物質 溶存オゾン 次亜塩素酸 次亜塩素酸 原料 水、酸素、空気 水、次亜塩素酸ナトリウム 塩酸、塩化ナトリウム 安定性 20~30分程度で濃度が半減する(実用上問題なし) 徐々に劣化するが数日は安定 遮光条件で数週間 残留性 なし(効能物質が酸素に変わるので問題なし) 次亜塩素酸が残留、または次亜塩素酸の分解した塩素が残留する 次亜塩素酸が残留、または次亜塩素酸の分解した塩素が残留する 危険性 高濃度のオゾンガスが揮発しない限り安全 塩素ガスが発生する 塩素ガスの発生は殆どない 殺菌能力 幅広い菌に効果がある 芽包菌に効果がない 幅広い菌に効果がある 主たる殺菌メカニズム O3→O2時の細胞膜の酸化分解 塩素化合物による酵素の阻害 塩素化合物による酵素の阻害 特徴 - 残留性がないので、殺菌作用の残留性もない
- 同時に除臭もできる
- 皮膚にやさしい
- シンクが錆びない
- アルカリ性雰囲気のため、有効になる塩素濃度が高い
- 刺激臭(反応時)
- 皮膚にやさしくない
- シンクが錆びることがある
- 塩素の殺菌効果が高いとされているpH域のため、有効塩素濃度が低くても効果が出る
- 刺激臭(反応時)
オゾン水の除臭効果
-
オゾン水の除臭力
酸素原子[O]3個からなるオゾン分子は不安定で、すぐに酸素に戻ろうとします。
この時離れた1つの酸素原子が様々な物質に付くことで、強い酸化反応を示します。
近くに臭いの原因物質があれば、その物質を酸化し、別の物質にすることで、臭いの元を無くし、除臭します。除臭できるもの
- アンモニア臭(アンモニア)
- 汗の臭い(ノルマル酪酸)
- 靴下の臭い(ノルマル吉草酸)
- 腐った魚の臭い(トルメチルアミン)
- 腐った卵の臭い(硫化水素)
- ホルムアルデヒド(ホルムアルデヒド)
除臭しにくいもの
- 揮発性有機化合物
-
他の除臭効果物質との比較
オゾン水 次亜塩素酸
ナトリウム溶液微酸性次亜塩素酸水 除臭メカニズム O3→O2時の酸化分解
(オゾンの酸化還元電位2.08V)CIO-を中心とした酸化
(CIO-の酸化還元電位0.42V)HCIOを中心とし、
CIO-も加わる酸化作用除臭能力 溶解する物質だけではなく、揮発する微量ガスで空間も除臭 溶解する物質を分解 溶解する物質を分解 デメリット 微量のオゾン臭がする アルカリ性なので危険
酸性物質と反応し塩素ガスを発生する有機物と反応すると塩素臭
(クロラミン)が生じる/酸性物質と反応すると塩素ガスを発生する特徴 噴霧することで空間除菌も可能(無人の空間) 高濃度で使用するためニオイの発生源の分解除去に使える 噴霧した場合において、霧に取り込まれた物質を除臭
オゾン水の安全性
-
ラットを用いる急性経口毒性(7mg/L)
一般症状の異常は認められず、死亡例はなし。
-
ウサギを用いる皮膚一次刺激性試験(7mg/L)
皮膚一次刺激性は有しない。
-
ウサギを用いる皮膚連続刺激性試験(7mg/L)
累積皮膚刺激性は有しない。
-
モルモットを用いたMaximization法による皮膚感作性試験(7mg/L)
皮膚感作性は有しない。
-
ウサギを用いる眼刺激性試験(7mg/L)
「無刺激物」の範疇。
-
マウスを用いた反復経口投与毒性試験(1.2mg/L)
異常および死亡なし。
-
ハムスターを用いた口腔粘膜刺激性試験(1.2mg/L)
ほとんど認められない。
出展 医療・環境オゾン研究 Vol.19 2012
日本医療・環境オゾン研究会会報 Vol.14 2007



